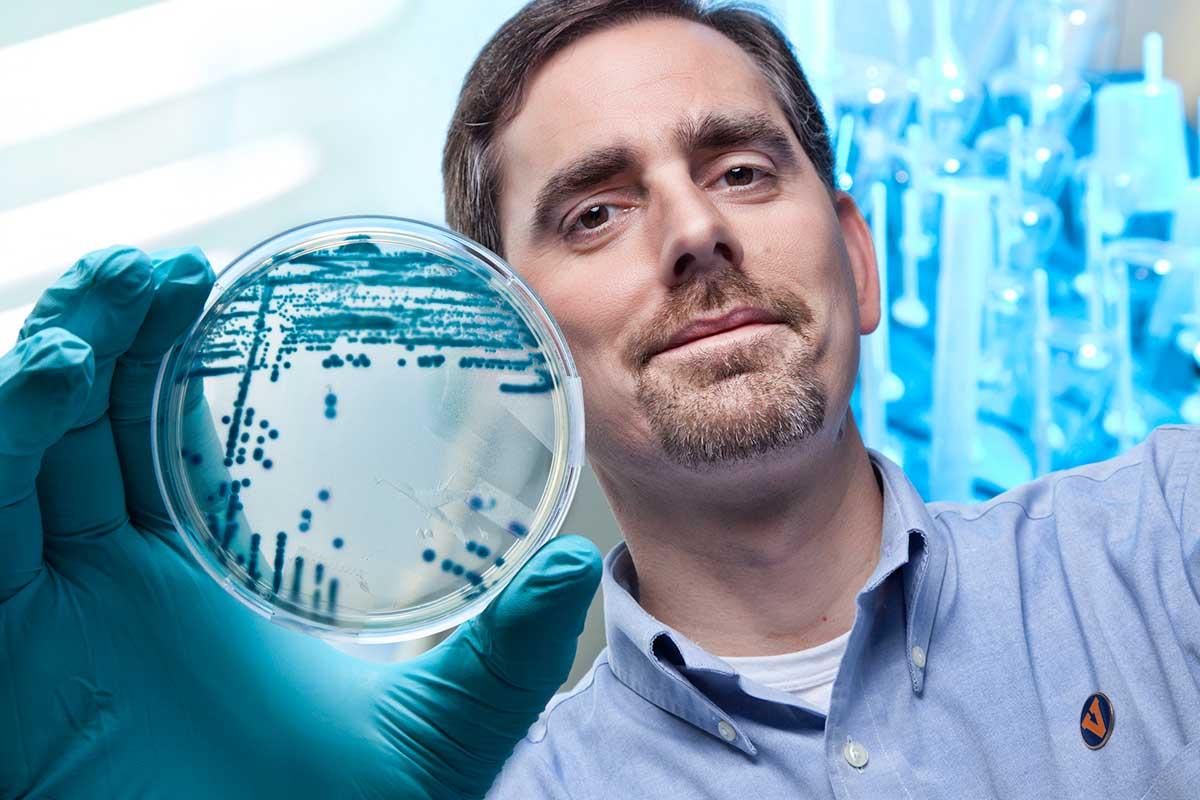
Dr. Sifri, an esteemed infectious disease physician at UVA Health, answers Dr. Kent's questions.

As Monkeypox Virus Cases Grow, Watch for the Rash & Other Symptoms

As of July 2022, there’s over 1,000 cases in the U.S, and over 40 cases of monkeypox virus in Virginia. However, experts agree that only a fraction of cases have been identified because recognizing symptoms and testing are challenging. Cases aren't spreading as quickly as COVID-19, and it rarely causes death. Still, our infectious disease experts encourage the public to educate themselves about monkeypox symptoms. Learn all the possible signs of this viral infection.
What Kind of Pox is It?
The word “pox” can be misleading. This virus is part of the same family as smallpox, but not chickenpox. A “pox” refers to a virus that causes a rash of pus-filled bumps.
Monkeypox Symptoms
Monkeypox symptoms include:
- Fever
- Headache
- Muscle ache or backache
- Swollen lymph nodes
- Chills
- Exhaustion
- A rash that looks like pimples or blisters
"Monkeypox is a viral illness, and so like other viral illnesses, there's a wide array of nonspecific symptoms that go along with that. Fever, chills, headache, malaise, these sorts of things," Patrick Jackson, MD, shares.
But some people only get the rash.
Monkeypox Rash
So many things can cause a rash. So how do you know if it’s monkeypox?
The monkeypox rash looks like pimples or blisters that may appear on the face, mouth, hands, feet, chest, genitals, or anus. The virus lasts 2-4 weeks before the rash completely heals. Some patients have reported that the rash is very painful and fills with pus that eventually crusts over.
What we're doing:
In May, our teams developed plans for patients who may have monkeypox. We're currently following all recommendations from the CDC and the Virginia Department of Health. Our teams will follow isolation protocols if a patient with monkeypox goes into the hospital. We will limit the number of team members entering the patient's room. We'll use virtual visits with patients not in the hospital.
"In some cases, people don't have this broad distribution of rash. Sometimes it's only in a small part of their body," Costi Sifri, MD, said.
If you’re worried about a rash, go to your doctor. But don’t stress out. Monkeypox tends to be a mild infection.
Cases may be rising, but Jackson stresses there's no need for alarm.
How This Virus Spreads Between People
The monkeypox virus spreads from person to person these ways:
- Direct contact with the infectious rash, scabs, or bodily fluids
- Respiratory fluids (from nose and mouth, like mucus) during intimate physical contact like kissing, cuddling, or sex
- Touching items like clothing or linens that touched the infectious rash or body fluids
- Pregnant people can spread the virus to the fetus through the placenta
Noticed a Rash?
Call a primary care provider if you noticed a rash and are concerned it could be monkeypox virus.
At this time, experts don’t believe it’s airborne or can linger in the air over long distances.
Monkeypox is contagious once symptoms start and until the rash has completely healed. It’s best to isolate at home in a separate room from others, including pets.
Watch What You Touch: Monkeypox Found on Surfaces
Right now, we can't rule out the possibility of getting monkeypox from touching a surface that an infected person touched. Researchers found the virus on hospitalized patients’ chairs, towels, shirts, pillowcases, handles, and one mobile phone.
A Possible Vaccine
In May 2022, President Biden took action to make vaccines, testing, and treatment available to those who need them as part of a national monkeypox vaccine strategy. A vaccine will help individuals at high risk.
Knowing the symptoms and being vigilant can help stop the spread of this virus, but this shouldn't turn into a pandemic like COVID-19.
Subscribe to Healthy Balance
Get timely health and wellness tips from UVA Health experts. Plus, stories that will move you.